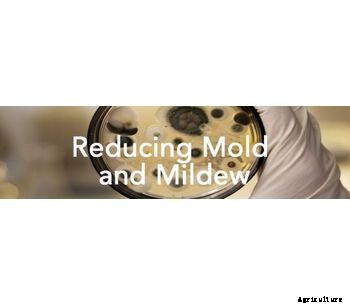
Jenfitch - Chemical for Reducing Mold and Mildew

JC 9450 is very effective in controlling mold and mildew. Using the energy of oxygen radicals, JC 9450 penetrates the mold and mildew quickly without damaging its surrounding. It has been effective in controlling mold and mildew in storage rooms and on fruit and vegetables too!! It is safe and simple to use. JC 9450 leaves no residue on the surface. If you are looking for a low cost method to remove mold and mildew, test JC 9450.